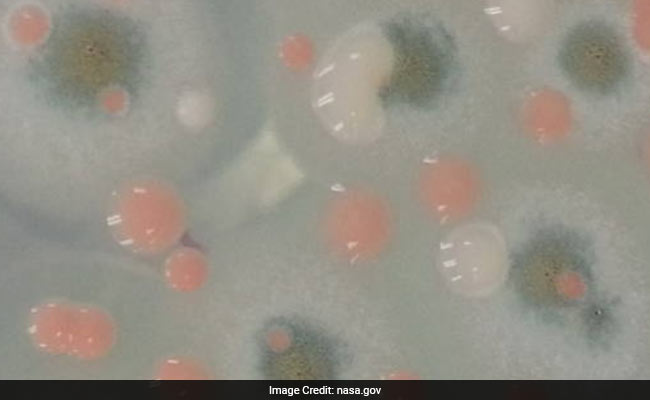
NASA To Explore Microbes Of Space Station

Microbial Explosion
-
{
- All
- News
'Microbial Explosion' - 2 News Result(s)
-

NASA To Explore Microbes Of Space Station
- Thursday September 22, 2016
- World News | Press Trust of India
NASA is planning to analyse the microbes that people have brought with them - and left behind - on the International Space Station to better understand how to control the microbial environment in future human exploration spacecraft.
-
 www.ndtv.com
www.ndtv.com
-

Pluto, Poop and Perils of Gene Editing: This Year's Best Science Stories
- Wednesday December 16, 2015
- Offbeat | Rachel Feltman, The Washington Post
This year has been a great year for scientific discovery - and an especially great year for space exploration.
-
 www.ndtv.com
www.ndtv.com
'Microbial Explosion' - 2 News Result(s)
-

NASA To Explore Microbes Of Space Station
- Thursday September 22, 2016
- World News | Press Trust of India
NASA is planning to analyse the microbes that people have brought with them - and left behind - on the International Space Station to better understand how to control the microbial environment in future human exploration spacecraft.
-
 www.ndtv.com
www.ndtv.com
-

Pluto, Poop and Perils of Gene Editing: This Year's Best Science Stories
- Wednesday December 16, 2015
- Offbeat | Rachel Feltman, The Washington Post
This year has been a great year for scientific discovery - and an especially great year for space exploration.
-
 www.ndtv.com
www.ndtv.com